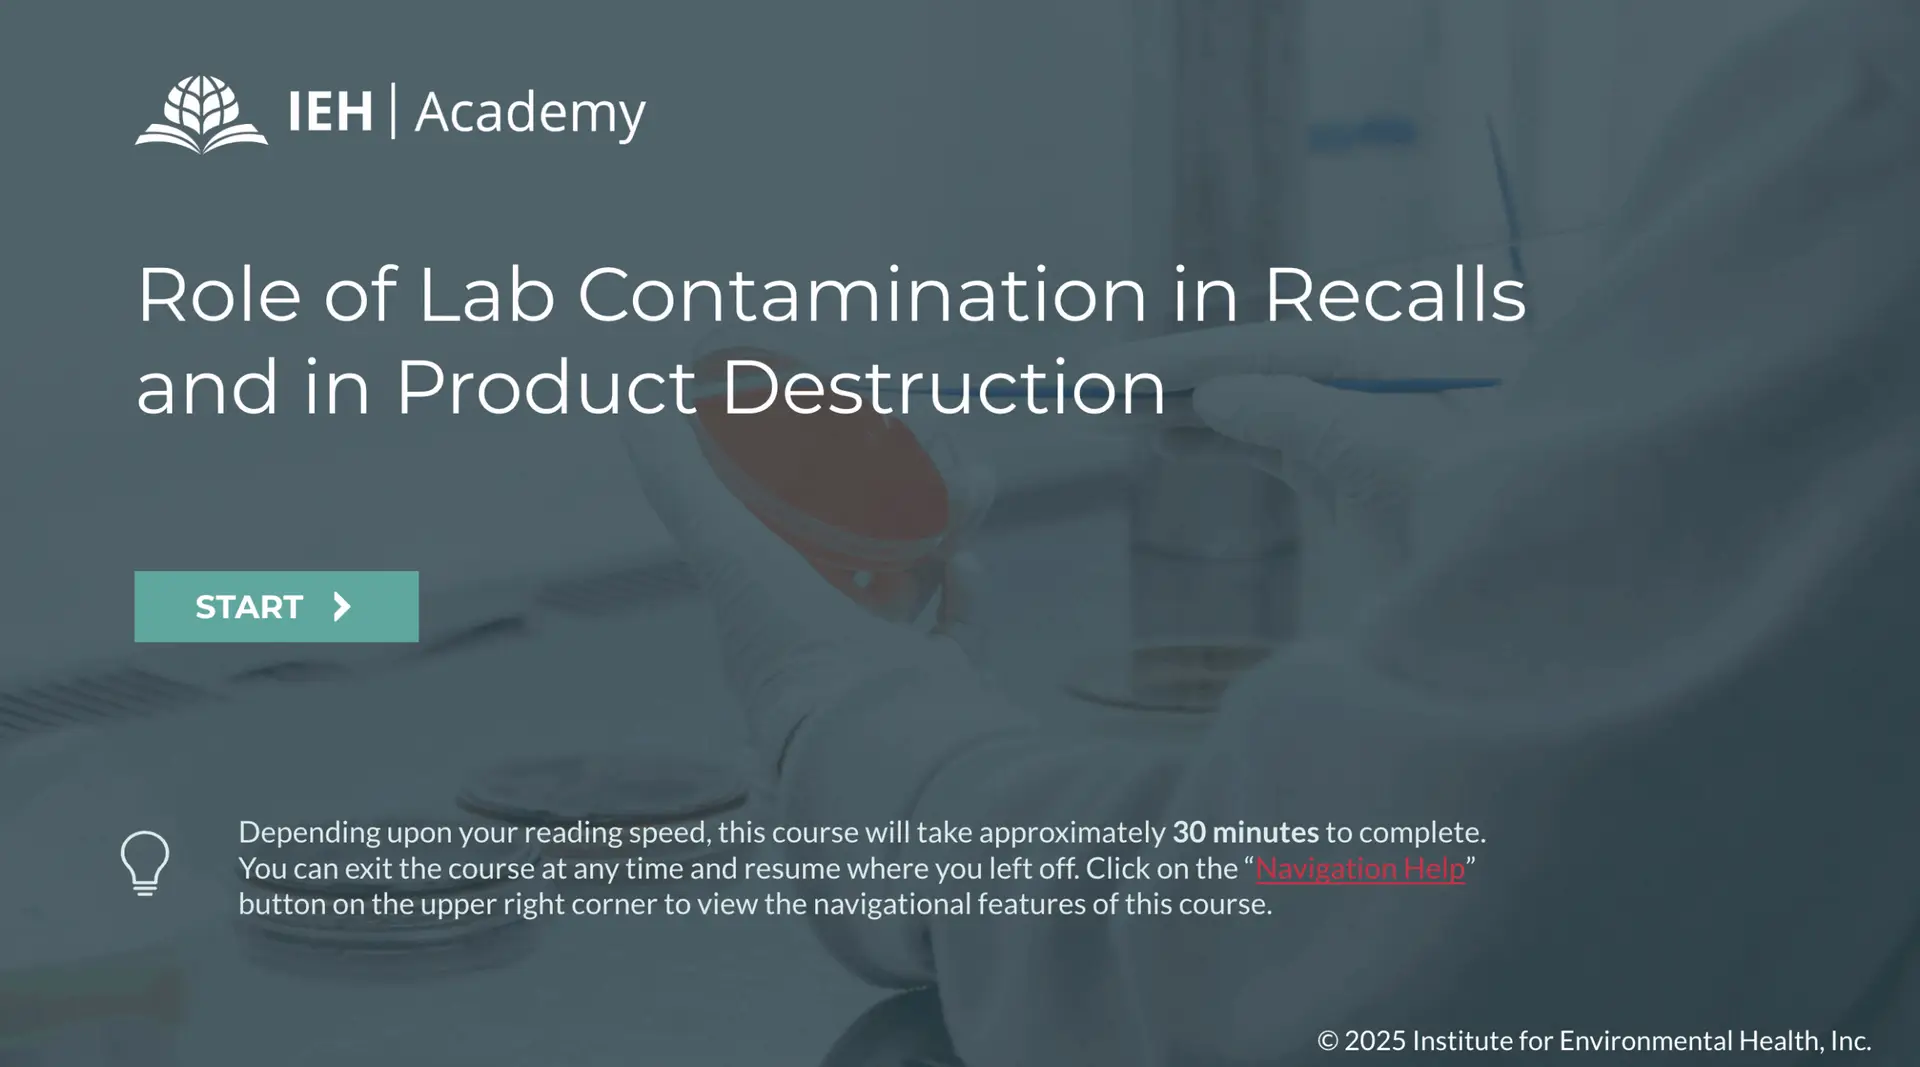
Screenshot one of course.

Role of Lab Contamination in Recalls and Product Destruction
Course details
Self-Paced eLearning
49.00
30 minutes
Thomas Hammack
Lab contamination is uncommon, but the consequences can be significant. From costly recalls to the destruction of otherwise safe products, even a single error can disrupt operations and damage a company’s reputation.
This course outlines how lab errors occur, how to identify them, and what steps companies can take to mitigate risk. Participants will examine case studies, common contamination pathways, and strategies for working with in-house and contract labs to manage unexpected positive results with confidence.
Benefits and Learning Objectives
- Explain how laboratory contamination can lead to recalls and product loss.
- Identify common causes of cross-contamination during laboratory testing.
- Evaluate evidence that supports or disproves lab-origin contamination.
- Describe steps to take when a finished product tests positive for a pathogen.
- Outline preventive practices labs should implement to reduce contamination risk.
- Understand what contract labs must provide in testing agreements.

Who Should Attend?
- Food safety and quality assurance professionals
- Industry leaders responsible for risk management and regulatory compliance
- Professionals overseeing pathogen testing and contamination prevention
- Decision makers evaluating in-house and contract lab testing reliability
Registration and Payment
To register for this course, please visit our training portal.

-
Vice President, Technical Services
IEH Laboratories & Consulting Group
Meet the Instructor
Thomas Hammack
Thomas Hammack joined IEH as Vice President of Technical Services in 2024. He has over 30 years of experience in the field of food microbiology, working at the FDA’s Center for Food Safety and Applied Nutrition (CFSAN). Starting in 1990, he began his tenure at the FDA as a research microbiologist until he became the Chief of the Microbial Methods Development Branch (MMDB) in 2009. In this role, he led a team of 25 microbiologists in developing and validating methods for the detection and characterization of bacterial pathogens and toxins in foods and on environmental surfaces. After a decade as Chief of MMDB, he concluded his tenure as a Senior Policy Analyst for Microbiology in CFSAN’s Office of Regulatory Science.
He is a co-author of FDA’s Bacteriological Analytical Manual’s (BAM) Salmonella, Cronobacter, and Food Sampling and Preparation of Sample Homogenate chapters. During his career, he Chaired the FDA’s Microbiology Methods Validation Subcommittee (MMVS) from 2017 to 2021, which oversees the validation of the microbiological methods used in the FDA’s Foods Program. He also chaired the FDA’s Bacteriological Analytical Manual (BAM) Council from 2009 to 2016. He remained a member of both the BAM Council and MMVS until his retirement at the end of 2023.
Thomas Hammack’s expertise extends beyond his roles at the FDA. He currently serves as an Expert Review Panel member for AOAC International, overseeing the validation of numerous methods for bacterial pathogens, including Salmonella, Listeria, and E. coli O157:H7. Since 2014, he has been a dedicated member of the MicroVal Technical Review Committee. Notably, he served as the Chair of the US Technical Advisory Group to ISO TC 34/SC 9 from 2011 to 2023, the committee responsible for the development of all ISO food microbiological methods.

-
Executive Vice President
IEH Laboratories & Consulting Group
Carol Cave
Ms. Carol Cave joined IEH as the Executive Vice President in 2024, bringing with her extensive expertise in regulatory affairs and consumer protection. She holds a B.S. in Consumer Economics from the University of Maryland.
Before joining IEH, Ms. Cave served as the Acting Associate Commissioner (ACRA) for the Office of Regulatory Affairs (ORA) at the Food and Drug Administration. In this role, she oversaw approximately 5000 ORA employees stationed across the U.S. and around the world.
Prior to her role as Acting ACRA, Ms. Cave served as Deputy Associate Commissioner, where she managed inspections, compliance, enforcement, field laboratory operations, import operations, and strategic planning.
Earlier in her career at the FDA, she served as the Assistant Commissioner of Import Operations, where she led the Office of Enforcement and Import Operations, ensuring FDA-regulated imported products comply with U.S. laws. Ms. Cave also led coordination efforts between the FDA and U.S. Customs and Border Protection, developing joint regulations, policies, procedures, and operations.
Before her tenure at the FDA, Ms. Cave was the Deputy Director of the Office of Compliance and Field Operations at the U.S. Consumer Product Safety Commission (CPSC). In this role, she collaborated with federal government agencies to identify potentially defective consumer products. With nearly 26 years at the CPSC, Ms. Cave held various leadership positions, including Director of State and Local Programs and Assistant Executive Director for the Office of Import Surveillance, ensuring the safety of consumer products nationwide.